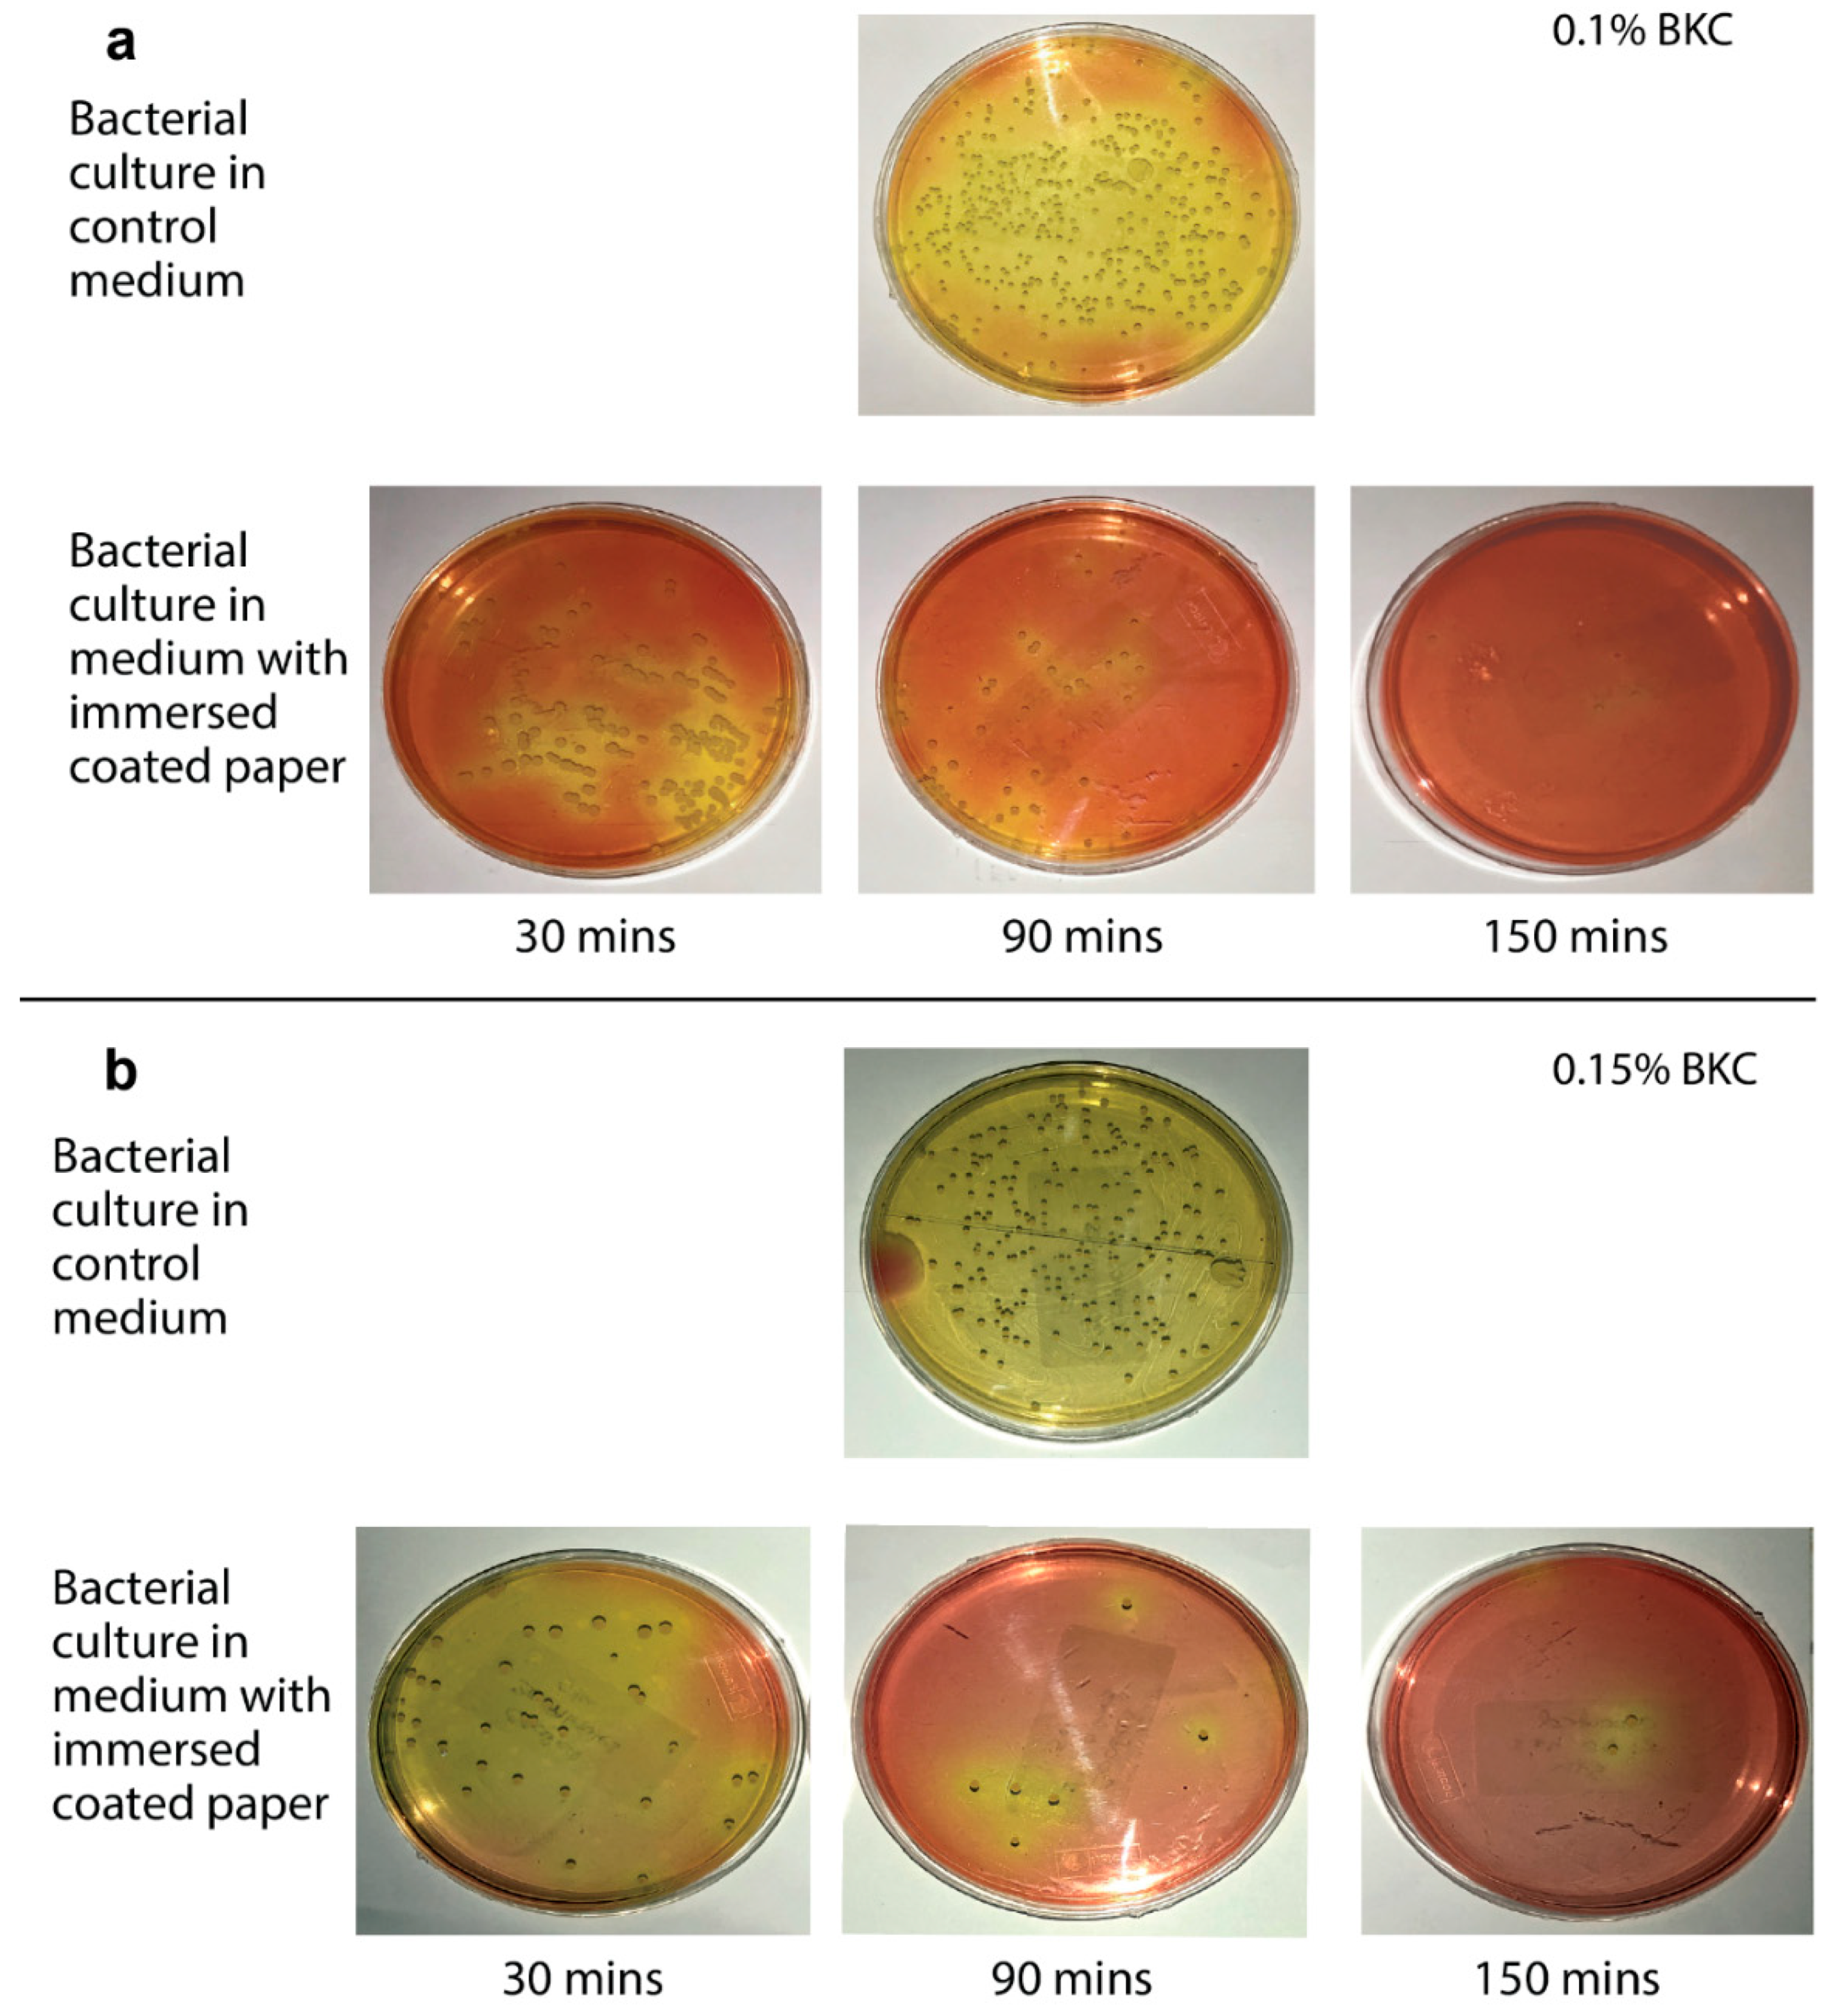
Chemengineering 05 00001 g002

Development of a Benzalkonium Chloride Based Antibacterial Paper for Health and Food Applications
Abstract
1. Introduction
2. Materials and Methods
2.1. Bacterial Strains, Culture Media and Agar Plate Preparation
2.2. Culture Media
2.3. Anti-Bacterial Paper Preparation
2.4. Culture Conditions
2.5. Measuring the Optical Density of Bacterial Culture
2.6. Preparation of Agar Plate
2.7. Analysis of Antibacterial Property
2.7.1. Immersion of Coated Paper into Bacterial Culture
2.7.2. Transfer of Bacterial Culture to Agar Plates
2.7.3. Final Titer Count
2.8. Analysis of Swelling Ratio of Coated Paper
3. Results and Discussion
3.1. Effect of Antibacterial Agent Concentration and Exposure Time
3.2. Analysis of Swelling Ratio of the Antibacterial Paper
4. Conclusions
Author Contributions
Funding
Institutional Review Board Statement
Informed Consent Statement
Data Availability Statement
Acknowledgments
Conflicts of Interest
References
- World Health Organization. WHO Estimates of the Global Burden of Foodborne Diseases: Foodborne Disease Burden Epidemiology Reference Group 2007–2015; World Health Organization: Gineva, Switzerland, 2015. [Google Scholar]
- Todd, E.C.D. Preliminary estimates of costs of foodborne disease in the United States. J. Food Prot. 1989, 52, 595–601. [Google Scholar] [CrossRef] [PubMed]
- Bitton, G. Microbiology of Drinking Water Production and Distribution; Wiley Online Library: Hoboken, NJ, USA, 2014; ISBN 1118743911. [Google Scholar]
- Alhamlan, F.S.; Al-Qahtani, A.A.; Al-Ahdal, M.N.A. Recommended advanced techniques for waterborne pathogen detection in developing countries. J. Infect. Dev. Ctries. 2015, 9, 128–135. [Google Scholar] [CrossRef] [PubMed]
- WHO/UNICEF. Millennium Development Goals: Progress on Sanitation and Drinking-Water: 2010 Update Report; WHO/UNICEF Joint Monitoring Programme for Water Supply: Geneva, Switzerland, 2010; ISBN 97892415639562010. [Google Scholar]
- Parolo, C.; Merkoçi, A. Paper-based nanobiosensors for diagnostics. Chem. Soc. Rev. 2013, 42, 450–457. [Google Scholar] [CrossRef] [PubMed]
- Pelton, R. Bioactive paper provides a low-cost platform for diagnostics. TrAC-Trends Anal. Chem. 2009, 28, 925–942. [Google Scholar] [CrossRef] [PubMed]
- Khan, M.S.; Thouas, G.; Shen, W.; Whyte, G.; Garnier, G. Paper diagnostic for instantaneous blood typing. Anal. Chem. 2010, 82, 4158–4164. [Google Scholar] [CrossRef]
- Islam, M.; Ahmed, I.; Anik, M.I.; Ferdous, M.; Khan, M.S. Developing paper based diagnostic technique to detect uric acid in urine. Front. Chem. 2018, 6, 496. [Google Scholar] [CrossRef]
- Khan, M.S.; Nabil, S.K.; Al Mahbub, H.; Khandaker, M.M.R. Bioactive Papers: A Futuristic Tool for Health, Food, and Environmental Applications. In Science and Technology Innovation for a Sustainable Economy; Springer: Berlin/Heidelberg, Germany, 2020; pp. 155–177. [Google Scholar]
- Tankhiwale, R.; Bajpai, S.K. Graft copolymerization onto cellulose-based filter paper and its further development as silver nanoparticles loaded antibacterial food-packaging material. Colloids Surf. B Biointerfaces 2009, 69, 164–168. [Google Scholar] [CrossRef]
- Hu, W.; Peng, C.; Luo, W.; Lv, M.; Li, X.; Li, D.; Huang, Q.; Fan, C. Graphene-based antibacterial paper. ACS Nano 2010, 4, 4317–4323. [Google Scholar] [CrossRef]
- Deokar, A.R.; Lin, L.-Y.; Chang, C.-C.; Ling, Y.-C. Single-walled carbon nanotube coated antibacterial paper: Preparation and mechanistic study. J. Mater. Chem. B 2013, 1, 2639–2646. [Google Scholar] [CrossRef]
- Ghule, K.; Ghule, A.V.; Chen, B.-J.; Ling, Y.-C. Preparation and characterization of ZnO nanoparticles coated paper and its antibacterial activity study. Green Chem. 2006, 8, 1034. [Google Scholar] [CrossRef]
- Gottesman, R.; Shukla, S.; Perkas, N.; Solovyov, L.A.; Nitzan, Y.; Gedanken, A. Sonochemical coating of paper by microbiocidal silver nanoparticles. Langmuir 2011, 27, 720–726. [Google Scholar] [CrossRef] [PubMed]
- McDonnell, G.; Russell, A.D. Antiseptics and disinfectants: Activity, action, and resistance. Clin. Microbiol. Rev. 2001, 14, 227. [Google Scholar] [CrossRef]
- Saito, K.; Hayakawa, T.; Kawabata, R.; Meguro, D.; Kasai, K. In vitro antibacterial and cytotoxicity assessments of an orthodontic bonding agent containing benzalkonium chloride. Angle Orthod. 2009, 79, 331–337. [Google Scholar] [CrossRef] [PubMed]
- Romanowski, E.G.; Mah, F.S.; Kowalski, R.P.; Yates, K.A.; Gordon, Y.J. Benzalkonium chloride enhances the antibacterial efficacy of gatifloxacin in an experimental rabbit model of intrastromal keratitis. J. Ocul. Pharmacol. Ther. 2008, 24, 380–384. [Google Scholar] [CrossRef] [PubMed]
- Richards, R.M.E.; Mizrahi, L.M. Differences in antibacterial activity of benzalkonium chloride. J. Pharm. Sci. 1978, 67, 380–383. [Google Scholar] [CrossRef]
- Morente, E.O.; Fernández-Fuentes, M.A.; Burgos, M.J.G.; Abriouel, H.; Pulido, R.P.; Gálvez, A. Biocide tolerance in bacteria. Int. J. Food Microbiol. 2013, 162, 13–25. [Google Scholar] [CrossRef]
- Jennings, M.C.; Minbiole, K.P.C.; Wuest, W.M. Quaternary Ammonium Compounds: An Antimicrobial Mainstay and Platform for Innovation to Address Bacterial Resistance. ACS Infect. Dis. 2016, 1, 288–303. [Google Scholar] [CrossRef]
- Ferreira, C.; Pereira, A.M.; Pereira, M.C.; Melo, L.F.; Simões, M. Physiological changes induced by the quaternary ammonium compound benzyldimethyldodecylammonium chloride on Pseudomonas fluorescens. J. Antimicrob. Chemother. 2011, 66, 1036–1043. [Google Scholar] [CrossRef]
- Wood, A.; Payne, D. The action of three antiseptics/disinfectants against enveloped and non-enveloped viruses. J. Hosp. Infect. 1998, 38, 283–295. [Google Scholar] [CrossRef]
- Wainberg, M.A.; Spira, B.; Bleau, G.; Thomas, R. Inactivation of human immunodeficiency virus type 1 in tissue culture fluid and in genital secretions by the spermicide benzalkonium chloride. J. Clin. Microbiol. 1990, 28, 156–158. [Google Scholar] [CrossRef]
- Bélec, L.; Tevi-Benissan, C.; Bianchi, A.; Cotigny, S.; Beumont-Mauviel, M.; Si-Mohamed, A.; Malkin, J.-E. In vitro inactivation of Chlamydia trachomatis and of a panel of DNA (HSV-2, CMV, adenovirus, BK virus) and RNA (RSV, enterovirus) viruses by the spermicide benzalkonium chloride. J. Antimicrob. Chemother. 2000, 46, 685–693. [Google Scholar] [CrossRef] [PubMed][Green Version]
- Armstrong, J.A.; Froelich, E.J. Inactivation of viruses by benzalkonium chloride. Appl. Microbiol. 1964, 12, 132–137. [Google Scholar] [CrossRef] [PubMed]
- Dyer, D.L.; Gerenratch, K.B.; Wadhams, P.S. Testing a new alcohol-free hand sanitizer to combat infection. AORN J. 1998, 68, 239–251. [Google Scholar] [CrossRef]
- Keen, P.L.; Montforts, M. Resistance in the Environment 2012; Wiley-Blackwell: Hoboken, NJ, USA, 2012. [Google Scholar]
- Krysinski, E.P.; Brown, L.J.; Marchisello, T.J. Effect of cleaners and sanitizers on Listeria monocytogenes attached to product contact surfaces. J. Food Prot. 1992, 55, 246–251. [Google Scholar] [CrossRef]
- Kuda, T.; Yano, T.; Kuda, M.T. Resistances to benzalkonium chloride of bacteria dried with food elements on stainless steel surface. LWT-Food Sci. Technol. 2008, 41, 988–993. [Google Scholar] [CrossRef]
- European Commission. European Parliament and Council Directive 98/8/EC of the European Parliament and of the Council of 16 February 1998 concerning the placing of biocidal products on the market. Off. J. Eur. Communities 1998, 41, 123. [Google Scholar]
- Basketter, D.A.; Marriott, M.; Gilmour, N.J.; White, I.R. Strong irritants masquerading as skin allergens: The case of benzalkonium chloride. Contact Dermat. 2004, 50, 213–217. [Google Scholar] [CrossRef] [PubMed]
- Arugonda, S.K. Quaternary ammonium compunds. In International Programme on Chemical Safety (IPCS); Poisons Information Monograph G 22: Dunedin, New Zealand, 1999. [Google Scholar]
- Dejobert, Y.; Martin, P.; Piette, E.; Thomas, P.; Bergoend, H. Contact dermatitis from didecyldimethylammonium chloride and bis-(aminopropyl)-laurylamine in a detergent-disinfectant used in hospital. Contact Dermat. 1997, 37, 95. [Google Scholar] [CrossRef]
- Marple, B.; Roland, P.; Benninger, M. Safety review of benzalkonium chloride used as a preservative in intranasal solutions: An overview of conflicting data and opinions. Otolaryngol. Neck Surg. 2004, 130, 131–141. [Google Scholar] [CrossRef]
- Pereira, B.M.P.; Tagkopoulos, I. Benzalkonium chlorides: Uses, regulatory status, and microbial resistance. Appl. Environ. Microbiol. 2019, 85. [Google Scholar] [CrossRef]
- Chang, Y.-C.; Yang, C.-Y.; Sun, R.-L.; Cheng, Y.-F.; Kao, W.-C.; Yang, P.-C. Rapid single cell detection of Staphylococcus aureus by aptamer-conjugated gold nanoparticles. Sci. Rep. 2013, 3, 1863. [Google Scholar] [CrossRef] [PubMed]
- Lin, H.-L.; Lin, C.-C.; Lin, Y.-J.; Lin, H.-C.; Shih, C.-M.; Chen, C.-R.; Huang, R.-N.; Kuo, T.-C. Revisiting with a relative-density calibration approach the determination of growth rates of microorganisms by use of optical density data from liquid cultures. Appl. Environ. Microbiol. 2010, 76, 1683–1685. [Google Scholar] [CrossRef] [PubMed]
- Wei, B.; Yang, G.; Hong, F. Preparation and evaluation of a kind of bacterial cellulose dry films with antibacterial properties. Carbohydr. Polym. 2011, 84, 533–538. [Google Scholar] [CrossRef]
- Ceragioli, M.; Mols, M.; Moezelaar, R.; Ghelardi, E.; Senesi, S.; Abee, T. Comparative transcriptomic and phenotypic analysis of the responses of Bacillus cereus to various disinfectant treatments. Appl. Environ. Microbiol. 2010, 76, 3352–3360. [Google Scholar] [CrossRef] [PubMed]
- Parsons, J.B.; Yao, J.; Frank, M.W.; Jackson, P.; Rock, C.O. Membrane disruption by antimicrobial fatty acids releases low-molecular-weight proteins from Staphylococcus aureus. J. Bacteriol. 2012, 194, 5294–5304. [Google Scholar] [CrossRef] [PubMed]
- Giesbrecht, P.; Kersten, T.; Maidhof, H.; Wecke, J. Staphylococcal cell wall: Morphogenesis and fatal variations in the presence of penicillin. Microbiol. Mol. Biol. Rev. 1998, 62, 1371–1414. [Google Scholar] [CrossRef]
- Imani, R.; Talaiepour, M.; Dutta, J.; Ghobadinezhad, M.R.; Hemmasi, A.H.; Nazhad, M.M. Production of antibacterial filter paper from wood cellulose. BioResources 2011, 6, 891–900. [Google Scholar] [CrossRef]
- Li, H.; Cui, R.; Peng, L.; Cai, S.; Li, P.; Lan, T. Preparation of antibacterial cellulose paper using layer-by-layer assembly for cooked beef preservation at ambient temperature. Polymers (Basel) 2018, 10, 15. [Google Scholar] [CrossRef]
- Kissa, E. Wetting and Wicking. Text. Res. J. 1996, 66, 660–668. [Google Scholar] [CrossRef]
- Akinli-Kocak, S. The Influence of Fiber Swelling on Paper Wetting; The University of Maine: Orono, ME, USA, 2001. [Google Scholar]
- Chronopoulou, L.; Margheritelli, S.; Toumia, Y.; Paradossi, G.; Bordi, F.; Sennato, S.; Palocci, C. Biosynthesis and characterization of cross-linked Fmoc peptide-based hydrogels for drug delivery applications. Gels 2015, 1, 179–193. [Google Scholar] [CrossRef]
- Masoodi, R.; Pillai, K.M. Darcy’s law-based model for wicking in paper-like swelling porous media. AIChE J. 2010, 56, 2257–2267. [Google Scholar] [CrossRef]

| Duration of Treatment (min) | Reduction in Viability (%)(1-N/N0) × 100% | ||
|---|---|---|---|
| Staphylococcus aureus | 0.1% BKC coated papers | 30 | 58.20 |
| 90 | 87.76 | ||
| 150 | 99.16 | ||
| 0.15% BKC coated papers | 30 | 80.00 | |
| 90 | 97.72 | ||
| 150 | 98.99 | ||
| 0.2% BKC coated papers | 30 | 94.34 | |
| 90 | 97.80 | ||
| 150 | 99.03 | ||
| Escherichia coli | 0.1% BKC coated papers | 30 | 74.67 |
| 90 | 90.78 | ||
| 150 | 91.85 | ||
| 0.15% BKC coated papers | 30 | 99.38 | |
| 90 | 99.31 | ||
| 150 | 100.00 | ||
| 0.2% BKC coated papers | 30 | 99.55 | |
| 90 | 100.00 | ||
| 150 | 100.00 | ||
| Sample No. | Dry Paper Weight W0 (g) | Swollen Paper Weight Wf (g) | Swelling Ratio (Wf − W0)/W0 |
|---|---|---|---|
| 1 | 0.2484 | 0.5988 | 1.415 |
| 2 | 0.2531 | 0.6070 | 1.398 |
| 3 | 0.2542 | 0.6133 | 1.413 |
| 4 | 0.2484 | 0.5991 | 1.412 |
| 5 | 0.2542 | 0.6026 | 1.371 |
| Average | 1.402 ± 0.0166 | ||
Publisher’s Note: MDPI stays neutral with regard to jurisdictional claims in published maps and institutional affiliations. |
© 2021 by the authors. Licensee MDPI, Basel, Switzerland. This article is an open access article distributed under the terms and conditions of the Creative Commons Attribution (CC BY) license (http://creativecommons.org/licenses/by/4.0/).
Share and Cite
Shadman, S.A.; Sadab, I.H.; Noor, M.S.; Khan, M.S. Development of a Benzalkonium Chloride Based Antibacterial Paper for Health and Food Applications. ChemEngineering 2021, 5, 1. https://doi.org/10.3390/chemengineering5010001
Shadman SA, Sadab IH, Noor MS, Khan MS. Development of a Benzalkonium Chloride Based Antibacterial Paper for Health and Food Applications. ChemEngineering. 2021; 5(1):1. https://doi.org/10.3390/chemengineering5010001
Chicago/Turabian StyleShadman, Swarit Ahmed, Ishmamul Hoque Sadab, Mohammed Sakib Noor, and Mohidus Samad Khan. 2021. "Development of a Benzalkonium Chloride Based Antibacterial Paper for Health and Food Applications" ChemEngineering 5, no. 1: 1. https://doi.org/10.3390/chemengineering5010001
APA StyleShadman, S. A., Sadab, I. H., Noor, M. S., & Khan, M. S. (2021). Development of a Benzalkonium Chloride Based Antibacterial Paper for Health and Food Applications. ChemEngineering, 5(1), 1. https://doi.org/10.3390/chemengineering5010001
